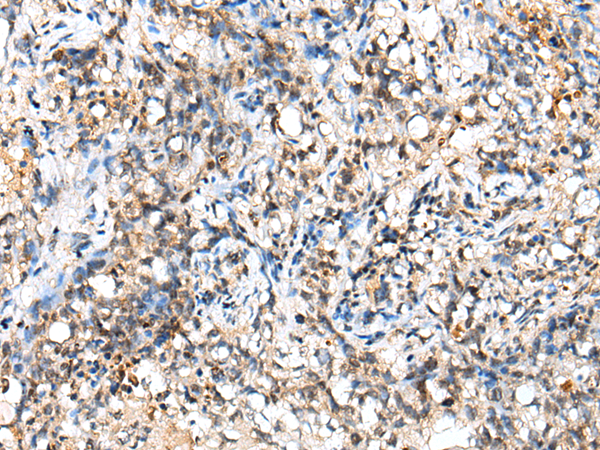

中文名稱: 兔抗NUDT18多克隆抗體
英文名稱: Anti-NUDT18 rabbit polyclonal antibody
別 名: MTH3
相關(guān)類別: 一抗
抗 原: NUDT18
儲 存: 冷凍(-20℃)
宿 主: Rabbit
反應(yīng)種屬: Human, Rat
標(biāo) 記 物: Unconjugate
克隆類型: rabbit polyclonal
技術(shù)規(guī)格
|
Background: |
The protein encoded by this gene is a member of the Nudix hydrolase family. Nudix hydrolases eliminate potentially toxic nucleotide metabolites from the cell and regulate the concentrations and availability of many different nucleotide substrates, cofactors, and signaling molecules. This protein contains a Nudix hydrolase domain and hydrolyzes oxidized forms of guanosine and deoxyguanosine diphosphates. |
|
Applications: |
ELISA, IHC |
|
Name of antibody: |
NUDT18 |
|
Immunogen: |
Fusion protein of human NUDT18 |
|
Full name: |
nudix (nucleoside diphosphate linked moiety X)-type motif 18 |
|
Synonyms: |
MTH3 |
|
SwissProt: |
Q6ZVK8 |
|
ELISA Recommended dilution: |
5000-10000 |
|
IHC positive control: |
Human lung cancer |
|
IHC Recommend dilution: |
30-150 |
購物車
幫助
021-54845833/15800441009
